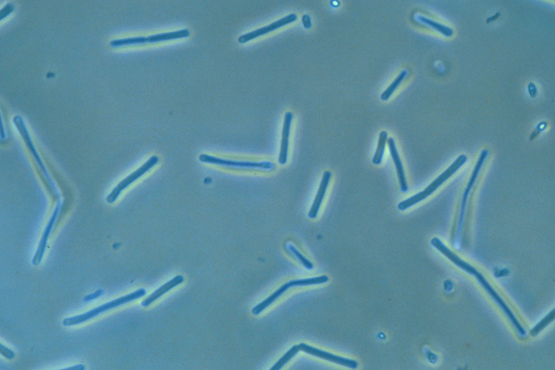

Clostridium Butyricum a strictly anaerobic spore-forming bacillus, is a common human and animal gut commensal bacterium, and is also frequently found in the environment.
When orally administered, C. butyricum spores germinate and grow in intestinal tracts and produce large amounts of SCFAs, such as butyrate and acetate. SCFAs constitute an important energy source for intestinal cells, and have proliferative effects on enterocytes. Additionally, SCFAs have been noted to have immune-modulatory effects on colonic inflammation. They suppress inflammatory cytokine secretion in cultured epithelial cells, facilitating tolerance of the intestinal mucosa to the presence of vast quantities of living microorganisms, and controlling the overgrowth of pathogens. It is therefore hypothesized, but not proven, that the main mechanism by which probiotic C. butyricum strains exert their beneficial effect is through equilibrated SCFA production.
HEALTH BENEFITS
- Helps digestion, maintains the integrity of the gastrointestinal tract mucosa
- Blocks the growth of pathogenic bacteria-Interferes with the growth of highly pathogenic, Clostridium difficile by antagonizing its multiplication.
- Secretes SCAFA.
- Helps the growth of beneficial bacteria like Bifidobacterium
- Helps in the treatment of Diarrhoea. It helps to regularize abnormal bowel movements during chronic Diarrhoea
- Clostridium butyricum also help in adjustment of water and electrolyte concentration of the intestinal tract
SPECIFICATION
| Appearance: | White to off white color powder |
| Loss on Drying: | NMT 5.0% |
| ASSAY: | 10 Million CFU, 10 Billion CFU, 100 Billion CFU, 300 Billion CFU |